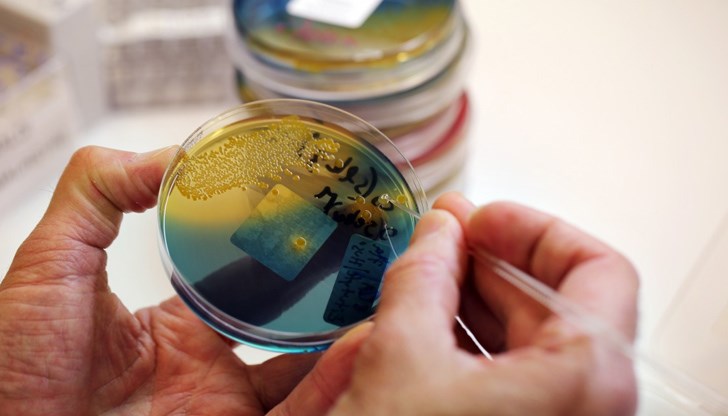

Нов супермикроб в сърцето на Европа
- Редактор: Петър Симеонов
- Коментари: 0
От заболявания, причинени от резистентни на антибиотици микроорганизми, умират до 700 000 души всяка година.
До средата на века тази цифра може да нарасне до 10 милиона, казват експерти от ООН. Опитите за строго регулиране на продажбата на антимикробни средства и ограничаване на тяхното използване в селското стопанство все още не са дали резултат. Супербактериите бързо се разпространяват по света и учените откриват нови микроорганизми, срещу които дори антибиотиците от последно поколение са безсилни. Какви опасности заплашват човечеството през новата година – в материала на РИА Новости, цитирани от БГНЕС.
Арктическа нечувствителност към антибиотици
Миналия февруари британски, американски и китайски изследователи откриха гена за антибиотична резистентност blaNDM-1 в бактерии, открити в Арктика. Микробите, които го имат в своята ДНК, са имунизирани срещу почти всички бета-лактами – най-многобройната и често срещана група антибиотици.
За първи път blaNDM-1 е описан през 2008 г. при клинични условия, през 2010 г. е открит в Индия. Според авторите, след пет години той е достигнал до отдалечения район Западен Шпицберген, вероятно с прелетни птици, зимуващи на Британските острови, или хора. Зарди микрофлората на архипелага опасният ген най-вероятно е пренесен от арктически лисици, които обичат да се ровят в боклука в близост до населени места.
Учените взеха проби от почвата в района на залива Конгсфьорден, изолираха микробна ДНК от тях и разкриха 131 гена за антибиотична резистентност. 39 бяха квалифицирани като автохтонни, тоест местни, само при наличие на стресови условия (например с високо съдържание на тежки метали в почвата). Но останалите, очевидно, са внесени, включително blaNDM-1.
Авторите на работата не са очаквали, че гените за антибиотична резистентност ще се разпространят толкова бързо.
Светкавичен обмен на опасни гени
Приблизително по същото време германски, датски и бразилски микробиолози предложиха възможно обяснение за такова бързо увеличение на броя на микроорганизмите, които са резистентни към няколко антибиотични групи наведнъж.
В продължение на 34 дни рибите Piaractus mesopotamicus, отглеждани в аквакултурите, се хранели с антибиотика флорфеникол. Тогава те взели проби от чревни бактерии от храносмилателния тракт на животните. Както се очаква, почти всички микроорганизми съдържат гени, които им позволяват да се противопоставят на флорфеникол. Но се оказа, че бактериите обменят полезни гени помежду си, като не използват плазмиди – ДНК молекули, изолирани от хромозоми, както се смяташе по-рано, а чрез вируси и мобилни генетични елементи (т. нар. скачащи гени).
Изследователите отбелязват, че това откритие трябва сериозно да коригира моделите на разпространение на гените за резистентност към антибиотици. Най-вероятно бактериалната антимикробна резистентност се предава много по-бързо.
Африкански бактерии със свръхспособности
През септември миналата година в Република Конго беше открит нов супермикроб – нетифозна салмонела, който се характеризира с повишена резистентност към антибиотици. Срещу тези бактерии са безсилни цефтриаксон и цефалоспорин – антимикробни лекарства от втора линия, обикновено препоръчвани за лечение на тежки чревни инфекции. Салмонелата също бсе оказа нечувствителна към азитромицин.
Освен това учените са открили, че този щам е загубил способността да образува биофилми и да оцелява в различни хранителни среди. С други думи, той се адаптира към човешкото тяло. Обикновено имунните клетки на човека реагират именно на него, което означава, че сега салмонелата е по-трудна за откриване и унищожаване.
Изследователите предполагат, че суперустойчивата салмонела се е появила в Конго не по-късно от 2004 г. и вече е успяла да се разпространи в поне три града в страната.
Нов супермикроб в сърцето на Европа
През октомври френски учени съобщиха, че с един от щамовете на Pseudomonas aeruginosa не може да се справи комбинирания антибиотик цефтолосан-тазобактам. Това е едно от лекарствата от последно поколение при лечение на тежки грам-отрицателни нозокомиални инфекции. Той може да причини сериозни странични ефекти, затова се използва само в крайни случаи, когато други лекарства не помагат.
Супермикробът е открит при френско дете, което е претърпяло операция на черния дроб два пъти и в продължение на две години е страдало от повтаряща се инфекция, причинена от Pseudomonas aeruginosa. Лекарите са предписали цефтолосан тазобактам. И след 22 дни в тялото на пациента е открит Pseudomonas aeruginosa, нечувствителен към антибиотици.
След като изследвали геномите на няколко десетки от неговите проби, учените открили, че антибиотичната резистентност е резултат от единична мутация в гена, който кодира ензима цефалоспориназа.
Те се борили с болестта 2,5 години. Оказа се, че придобивайки нечувствителност към антибиотика, Pseudomonas aeruginosa зе загубил защита от други лекарства. Така че е вероятно да победим някои супербактерии с помощта на по-стари средства.























Хванаха пенсионер с фалшива банкнота от 500 евро в Габрово
Трима медици бяха пребити за седмица във Великотърновско
Румен Радев: Готови сме за битка
Румен Радев: Готови сме за битка
Румен Радев: Готови сме за битка